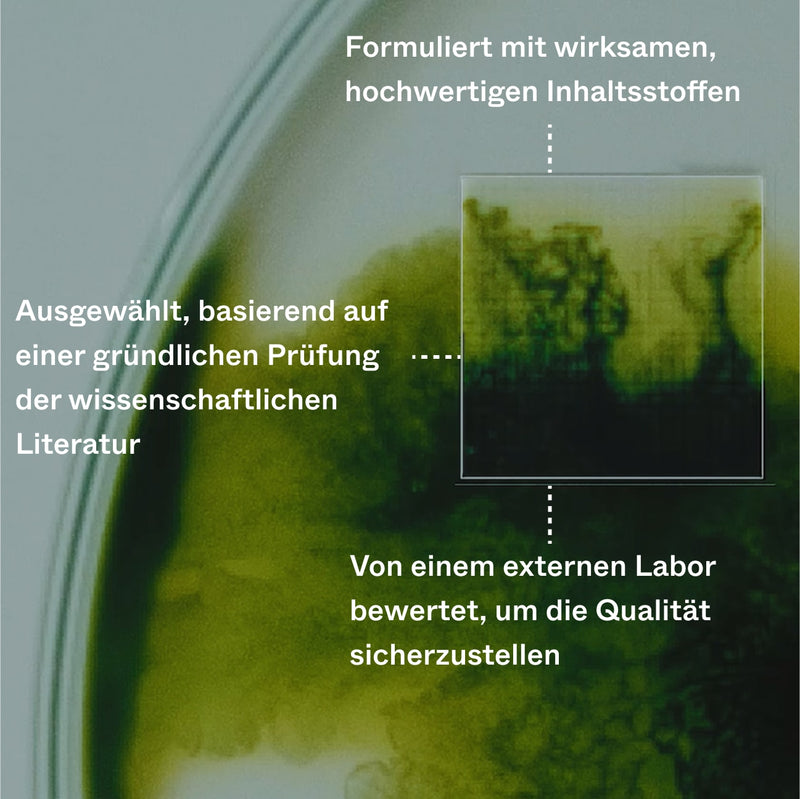

Das Beste Serum
"Top Produkt, sehr gut verträglich, nehme es seit 2 Jahren und es hilft prima. Geduld und eine regelmäßige Behandlung sind sehr wichtig."

Abonniere & Spare: Einmalkauf:
/
Gratiszugang zu Headspace
Pausiere oder kündige jederzeit
Gratisgeschenk enthalten
Das bewirkt es:
Pflegt die Haarfollikel und fördert das Wachstum
Entwickelt mit Experten und unterstützt durch Stammzellentechnologie
Klinisch getestet für sichtbare Ergebnisse
Pflanzenbasiert
Ohne Medikamente
Dermatologisch getestet

Capilia Longa™
Eine natürliche wirksame Bindung, die in einzelnen Studien eine Reduzierung von Haarausfall bis zu 89% sowie eine Verbesserung der Haardichte bis zu 52% aufzeigt.

Niacinamid
Niacinamid kann zu stärkerem Haar beitragen, indem es die Keratinproduktion stimuliert, welches ein Schlüsselprotein ist und etwa 90% des Haarschafts ausmacht.

Aloe Vera
Forschungen zeigen, dass Aloe-Vera-Extrakt dabei helfen kann, gereizte Kopfhaut zu beruhigen und den Wasserverlust der Haut zu reduzieren, wenn diese trocken und geschädigt ist.
Wir haben unsere Bio-Pilixin®-Formel unabhängigen klinischen Tests unterzogen, um sicherzustellen, dass sie in der Praxis wirkt – nicht nur auf dem Papier. Die Ergebnisse:
Bereits nach 45 Tagen wurde von sichtbaren Ergebnissen berichtet
93 % hatten klinisch getestet weniger Haarausfall
73 % verzeichneten eine messbar höhere Haardichte
90 % zeigten einen verbesserten Haarwachstumszyklus


Jessica
Using Bio-Pilixin® Activation Serum


Lora
Using Bio-Pilixin® Activation Serum


Sophie
Using Bio-Pilixin® Activation Serum


Mitra
Using Bio-Pilixin® Activation Serum


Karen
Using Bio-Pilixin® Activation Serum


Anne
Using Bio-Pilixin® Activation Serum


Shannon
Using Bio-Pilixin® Activation Serum


Anna Maria
Using Bio-Pilixin® Activation Serum
Wird es bei mir wirken?
Erfahren Sie, wie unsere Formel die Haarfollikel anspricht, die Durchblutung fördert und sichtbares Wachstum unterstützt.
Erkenne zurückgehendes Haar frühzeitig mit präziser Zielgenauigkeit
Ein leichtes Spray, um entspannte Styles mit Textur und Volumen zu kreieren und gleichzeitig die Haarintegrität in den Vordergrund zu stellen.
Drei Wege, wie Bio-Pilixin® die Ursache bekämpft
Wenn Follikel zu lange ruhen, wird das Haar dünner, bevor es ganz aufhört zu wachsen. Bio-Pilixin® kann helfen, den Zyklus wieder ins Gleichgewicht zu bringen.
Klinische Tests zeigen, dass Bio-Pilixin® helfen kann, den Haarwachstumszyklus wiederherzustellen.
93%
berichteten von weniger Haarausfall
73%
zeigten erhöhte Haardichte

Unsere Formel nutzt pflanzliche Stammzellen, Wachstumsfaktoren und Peptide aus Capilia Longa™, um ruhende Follikel wieder zu aktivieren.
Edna Skopljak, Ärztin (MD)
Viele Produkte bleiben auf der Kopfhaut oder werden vom umliegenden Gewebe aufgenommen und erreichen nie die Follikel, wo das Wachstum stattfindet.
Bio-Pilixin® nutzt pflanzliche Exosomen, um aktive Inhaltsstoffe tief in die Kopfhaut zu transportieren.
Bis zu 462x
kleiner als Poren
2,87 Milliarden
Exosomen pro Tagesdosis

Basierend auf der täglichen Anwendung von 2 vollen Pipetten Bio-Pilixin® Activation Serum
Edna Skopljak, Ärztin (MD)
Eine schlechte Durchblutung der Kopfhaut entzieht den Follikeln Sauerstoff und Nährstoffe, die für das Wachstum notwendig sind. Bio-Pilixin® enthält HotFlux® – ein sanft wärmender Wirkstoff, der die Durchblutung fördert.
Wir haben die Aktivität der Kopfhaut nach dem Auftragen von Bio-Pilixin® gemessen
Messung der Mikrozirkulation


Wenn Follikel zu lange ruhen, wird das Haar dünner, bevor es ganz aufhört zu wachsen. Bio-Pilixin® kann helfen, den Zyklus wieder ins Gleichgewicht zu bringen.
Klinische Tests zeigen, dass Bio-Pilixin® helfen kann, den Haarwachstumszyklus wiederherzustellen.
93%
berichteten von weniger Haarausfall
73%
zeigten erhöhte Haardichte

Unsere Formel nutzt pflanzliche Stammzellen, Wachstumsfaktoren und Peptide aus Capilia Longa™, um ruhende Follikel wieder zu aktivieren.
Edna Skopljak, Ärztin (MD)
Viele Produkte bleiben auf der Kopfhaut oder werden vom umliegenden Gewebe aufgenommen und erreichen nie die Follikel, wo das Wachstum stattfindet.
Bio-Pilixin® nutzt pflanzliche Exosomen, um aktive Inhaltsstoffe tief in die Kopfhaut zu transportieren.
Bis zu 462x
kleiner als Poren
2,87 Milliarden
Exosomen pro Tagesdosis

Basierend auf der täglichen Anwendung von 2 vollen Pipetten Bio-Pilixin® Activation Serum
Edna Skopljak, Ärztin (MD)
Eine schlechte Durchblutung der Kopfhaut entzieht den Follikeln Sauerstoff und Nährstoffe, die für das Wachstum notwendig sind. Bio-Pilixin® enthält HotFlux® – ein sanft wärmender Wirkstoff, der die Durchblutung fördert.
Wir haben die Aktivität der Kopfhaut nach dem Auftragen von Bio-Pilixin® gemessen
Messung der Mikrozirkulation


Wissenschaftlich unterstützte Wirkstoffe schaffen die richtige Umgebung für gesundes Haarwachstum.
Eine natürliche wirksame Bindung, die in einzelnen Studien eine Reduzierung von Haarausfall bis zu 89% sowie eine Verbesserung der Haardichte bis zu 52% aufzeigt.
VORTEILE
Kann Haarausfall messbar reduzieren
Kann die Haardichte nach 150 Tagen sichtbar erhöhen
Hilft das Haar stark zu halten, indem es die Lebensdauer von Haarfasern verlängert
Niacinamid kann zu stärkerem Haar beitragen, indem es die Keratinproduktion stimuliert, welches ein Schlüsselprotein ist und etwa 90% des Haarschafts ausmacht.
VORTEILE
Kann das Haar stärken, indem es die Keratinproduktion stimuliert
Schützt vor oxidativem Stress
Hilft Haarausfall zu reduzieren, indem die Durchblutung verbessert wird
Forschungen zeigen, dass Aloe-Vera-Extrakt dabei helfen kann, gereizte Kopfhaut zu beruhigen und den Wasserverlust der Haut zu reduzieren, wenn diese trocken und geschädigt ist.
VORTEILE
Fördert eine hydratisierte Kopfhaut
Kann gereizte Haut beruhigen
Trägt zu einer verbesserten Haarstärke und Struktur bei
Es hat sich gezeigt, dass Aminosäuren den Zustand von geschädigtem Haar verbessern, indem sie die Gesamtstärke und Langlebigkeit des Haares erhöhen.
VORTEILE
Fördert die Reparatur von Schäden
Fördert stärkeres, widerstandsfähiges Haar
Hilft das Haar mit Feuchtigkeit zu versorgen
Ein mild-wärmendes Mittel, das ein prickelndes Gefühl auf der Kopfhaut erzeugen kann. Dies kann die Durchblutung (die Nährstoff- und Sauerstoffversorgung) der Kopfhaut verbessern.
VORTEILE
Hilft die Durchblutung der Kopfhaut zu verbessern
Trägt zu einer erhöhten Sauerstoff- und Nährstoffversorgung bei
Fördert das Haarwachstum
Zink PCA ist aufgrund seiner Fähigkeit, die Ölproduktion zu regulieren, ohne die Haut dabei zu reizen, ein beliebter Inhaltsstoff in Kosmetika.
VORTEILE
Hilft Fettigkeit und Reizungen zu reduzieren
Trägt zu einem sauberen, frischen Aussehen bei
Anti-Pilz-Eigenschaften helfen Schuppen zu reduzieren
Pflanzlich basiert
Unterstützt Follikelfunktion
Wissenschaftlich belegt
Ohne Medikamente
Noch Fragen? Schau in unser Help Center oder schreibe uns: kontakt@scandinavianbiolabs.de
Eine klinische Studie zur Wirksamkeit von Bio-Pilixin® hat ergeben, dass der Haarausfall bereits nach 45 Tagen der Anwendung zurückgeht. Es dauert jedoch bis zu 150 Tage, um die volle Wirkung von Bio-Pilixin® zu sehen, einschließlich einer Zunahme der Haardichte und einer positiven Beeinflussung des Haarwachstumszyklus
Hier kannst du die vollständige klinische Studie über die Bio-Pilixin ® Formel lesen
Wir beginnen unsere Forschung immer in der Natur, hören dort aber nie auf. Sobald wir Inhaltsstoffe finden, die durch wissenschaftliche Literatur belegt sind, nutzen wir Biotechnologie, um sie zu optimieren. Manchmal geht es darum, das Beste abzuleiten, was eine Verbindung zu bieten hat. In anderen Fällen wird die gleiche Verbindung im Labor nachgebildet.
Klinische Tests unserer Bio-Pilixin®-Formel haben die Wirksamkeit unseres Ansatzes bestätigt: 77 % der Teilnehmer verzeichneten bereits nach 45 Tagen eine Verringerung des Haarausfalls und 93 % nach 150 Tagen. 73 % verzeichneten nach 150 Tagen eine messbare Zunahme der Haardichte.
Wenn Sie nach 150 Tagen Anwendung Ihres Bio-Pilixin®-Produkts keine Ergebnisse sehen, erstatten wir Ihnen Ihr Geld – ohne Aufwand und ohne versteckte Bedingungen.
Um sich zu qualifizieren, befolgen Sie einfach diese drei einfachen Schritte:
Dokumentieren Sie Ihre Reise:
Machen Sie jeden Monat ein Foto des behandelten Bereichs.
Tägliche Anwendung:
Verwenden Sie Ihr Bio-Pilixin®-Produkt jeden Tag über 150 aufeinanderfolgende Tage (etwa fünf Flaschen oder Tuben).
Reichen Sie Ihren Anspruch ein:
Wenn Sie nach 150 Tagen keine Ergebnisse sehen und die unten genannten Bedingungen erfüllen, klicken Sie hier, um Ihre Garantie zu beanspruchen.
Qualifizierte Produkte:
Bio-Pilixin® Hairline Booster
Bio-Pilixin® Activation Serum
Bio-Pilixin® Eyelash Growth Serum
Bedingungen:
Ansprüche müssen innerhalb von vier Monaten nach Abschluss der 150 Tage eingereicht werden.
Die Garantie deckt bis zu fünf Produkte ab (ausreichend für einen vollständigen 150-Tage-Zeitraum).
Nur die oben aufgeführten Produkte sind abgedeckt – andere Produkte wie Shampoo oder Conditioner sind ausgeschlossen.
Fotodokumentation Ihres Fortschritts (oder dessen Ausbleiben) ist erforderlich.
Gilt nur für Erstkäufe, die direkt über unseren offiziellen Shop getätigt wurden.
Warum 150 Tage?
In klinischen Studien zeigten 97 % der Benutzer nach 150 Tagen konsequenter Anwendung sichtbare Ergebnisse. Haarwachstum braucht Zeit – und wir möchten, dass Sie die volle Wirkung erleben, bevor Sie entscheiden.
Garantie beanspruchen
Hier kannst du die vollständige klinische Studie über die Bio-Pilixin ® Formel lesen
Wir haben Bio-Pilixin® nicht in einem Vergleichsversuch mit anderen Optionen getestet. Wenn du herausfinden möchtest, wie Bio-Pilixin® in klinischen Tests abgeschnitten hat, findest du hier die wichtigsten Ergebnisse:
77 % berichteten bereits nach 45 Tagen von spürbar weniger Haarausfall
Bei 93 % konnte nach 150 Tagen eine nachweisliche Reduzierung des Haarausfalls festgestellt werden
73 % verzeichneten nach 150 Tagen eine messbare Zunahme der Haardichte
Du kannst hier mehr lesen.
In einem klinischen Wirksamkeitstest unseres Bio-Pilixin® Hair Activation Serums stellten 77 % der Teilnehmer bereits nach 45 Tagen täglicher Anwendung eine Verringerung des Haarausfalls fest, und 93 % nach 150 Tagen. 73 % verzeichneten nach 150 Tagen eine messbare Zunahme der Haardichte.
Bio-Pilixin® ist kein Arzneimittel, sondern eine bio-harmonisierte funktionelle kosmetische Lösung. Daher haben wir es nicht gegen oder zusammen mit anderen pharmazeutischen Produkten getestet und können daher keine Angaben zur Kompatibilität machen.
Wenn du von anderen Optionen auf unsere Produkte umsteigen oder diese gemeinsam verwenden möchtest, empfehlen wir immer, mit einem medizinischen Fachpersonal zu sprechen.
Unsere Produkte werden mit kosmetischen Inhaltsstoffen hergestellt und sind frei von Medikamenten und ähnlichen Inhaltsstoffen. Das bedeutet, dass sie keine Inhaltsstoffe wie herkömmliche Optionen enthalten. Alle unsere Produkte sind gemäß EU-Gesetzgebung sicherheitsgeprüft und enthalten Inhaltsstoffe, für deren Verwendung strenge Sicherheitsdaten vorliegen müssen.
Wir testen alle unsere Produkte ebenso dermatologisch auf Nebenwirkungen. Abhängig von deiner persönlichen Situation können jedoch bei jedem Produkt Nebenwirkungen wie Hautreizungen auftreten. Wir empfehlen immer, unsere Produkte vor der Verwendung einem Patch-Test zu unterziehen oder im Zweifelsfall einen Arzt zu konsultieren.
Hier kannst du die vollständige klinische Studie über die Bio-Pilixin ® Formel lesen
Ja, an einer Gruppe von 25 Freiwilligen mit normaler Haut wurden unter dermatologischer Kontrolle “Patch-Tests” durchgeführt. Es traten keine Reizungen oder allergischen Reaktionen auf.
Hier kannst du die vollständige klinische Studie über die Bio-Pilixin ® Formel lesen
Bei der Anwendung des Bio-Pilixin® Activation Serums ist typischerweise ein „Kribbeln“ oder „Brennen“ zu spüren, was bei der Anwendung als normale Reaktion gilt. Das Gefühl wird dem Heizmittel HotFlux® oder Vanillylbutylether zugeschrieben, das zur Verjüngung des Haarwachstums beiträgt.
Die Intensität variiert je nach Person und reicht von minimaler Auffälligkeit bis hin zu Reizbarkeit. Die meisten Fälle verlaufen mild, in seltenen Fällen können jedoch Rötungen und Druckempfindlichkeit auftreten. Wenn weitere Nebenwirkungen auftreten, breche die Anwendung ab und konsultiere einen Arzt. Bitte melde alle weiteren Nebenwirkungen unserem Kundendienst.
Obwohl alle unsere Produkte dermatologisch getestet sind, sind sie nicht allergenfrei. Vanillylbutylether und Eukalyptusöl (Limonen) haben sensibilisierende Eigenschaften, was bedeutet, dass sie bei bestimmten Personen Allergien auslösen können. Es wird dringend empfohlen, vor Beginn alle Inhaltsstoffe zu überprüfen, um sicherzustellen, dass du keine Allergien gegen die aufgeführten Inhaltsstoffe hast.
Wenn du dir nicht sicher bist, führe vor der Anwendung einen Patch-Test durch. Um einen Patch-Test durchzuführen, trage einfach eine kleine Menge des Produkts auf eine saubere Hautstelle am oberen Unterarm auf und spüle die Stelle nach 24 Stunden ab. Wenn während des Tests zu irgendeinem Zeitpunkt Rötungen, Juckreiz, Blasenbildung oder Reizungen beobachtet werden, verwende das Produkt nicht.
Der Alkohol in der Bio-Pilixin®-Formulierung ist unerlässlich, um die Wirkung der Wirkstoffe zu ermöglichen. Der Alkohol dient als Mittel zur Optimierung des Kopfhautmilieus.
Overall rating: 4.4217687 / 5 from 294 reviews.
Bio-Pilixin Activation Serum is designed to reduce hair loss and promote hair growth. Customers appreciate its easy application and pleasant scent, though opinions vary on its effectiveness and ingredients.
Review topics: [results, ingredients, irritation, service, improvement, feels, packaging, problem, hair, scalp, sensation, scent, bottle, looks, quality, price, skin, fragrance, work, use, difference, effect, serum, treatment, growth, application, instructions, falls, becomes, shampoo].
"Top Produkt, sehr gut verträglich, nehme es seit 2 Jahren und es hilft prima. Geduld und eine regelmäßige Behandlung sind sehr wichtig."
"Nach ca. 1 Monat habe ich feststellen können dass viel weniger Haare im Abfluss landeten. Jetzt verwende ich es seit 4,5 Monaten und kann jetzt die ersten Babyhaare am Ansatz sehen. Insgesamt habe ich das Gefühl dass sie fester sind und wieder an Fülle gewinnen. Das einzige Manko ist dass sich das Serum auf trockenem Haar etwas klebrig anfühlt. Dahe trage ich es auf noch feuchtes (nicht nasses) Haar auf. Fühlt sich für mich besser an."
"Nach 1 Woche hatte ich kein Haarausfall mehr und nach 2 Monaten könnte ich schon Verbesserung feststellen. Ich bin sehr zufrieden und werde es weiterempfehlen."
"After using different lotions and not getting results, I was skeptical when I started using this serum. I can see a lot of new hair in the places where there were gaps in my hairline. Hope to see improvements in the next months ."
"Während ich an Anfang richtig gesehen habe, wie kleine Haare wieder wachsen, ist aktuell ein Stillstand eingetreten, obwohl ich Shampoo, Conditioner dun Serum verwende."
"for almost two weeks now using the serum and hair nutrient tabs , it’s a big help. Hair loss got lesser and lesser. Thanks to this Scandinavian product really to be trusted and legit."
"Ein sehr gute Produkt. Tatsächlich man kann sehen echte Ergebnisse . Ich bin sehr zufrieden weil ich habe gefunden ein Produkt das nicht meine Kopfhaut irritiert"
"I‘m using the Serum since 1 year and the results are incredible. I have fuller and healthier hair, I use it twice a day and wouldnt go without it anymore."
"Ich bin sehr zufrieden mit dem Serum und Haarshampoo. Beides ist regelmäßig im Einsatz und hat mir wieder etwas mehr Fülle gegeben."
"Ich nutze es nun schon einige Monate und mittlerweile bin ich mich reaötiv sicher, dass es gegen meinen Haarausfall wirkt. Ich konnte aufgrund meiner Schwangerschaft und Stillzeit Minoxidil nicht verwenden und habe dieses Serum als Ersatz verwendet. Es ist zwar viel teurer, aber schon nach ein paar Wochen hat sich mein Haar wieder gepflegter und geschmeidiger angefühlt und ich habe deutlich weniger Haare verloren."